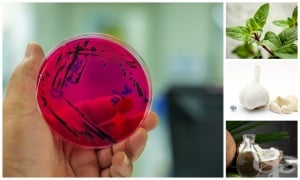
����� � ������� �������� ����� ������������� ��������

Здравна библиотека
Диагностик
Здравна помощ
Здраве и начин на живот
За нас
Контакти